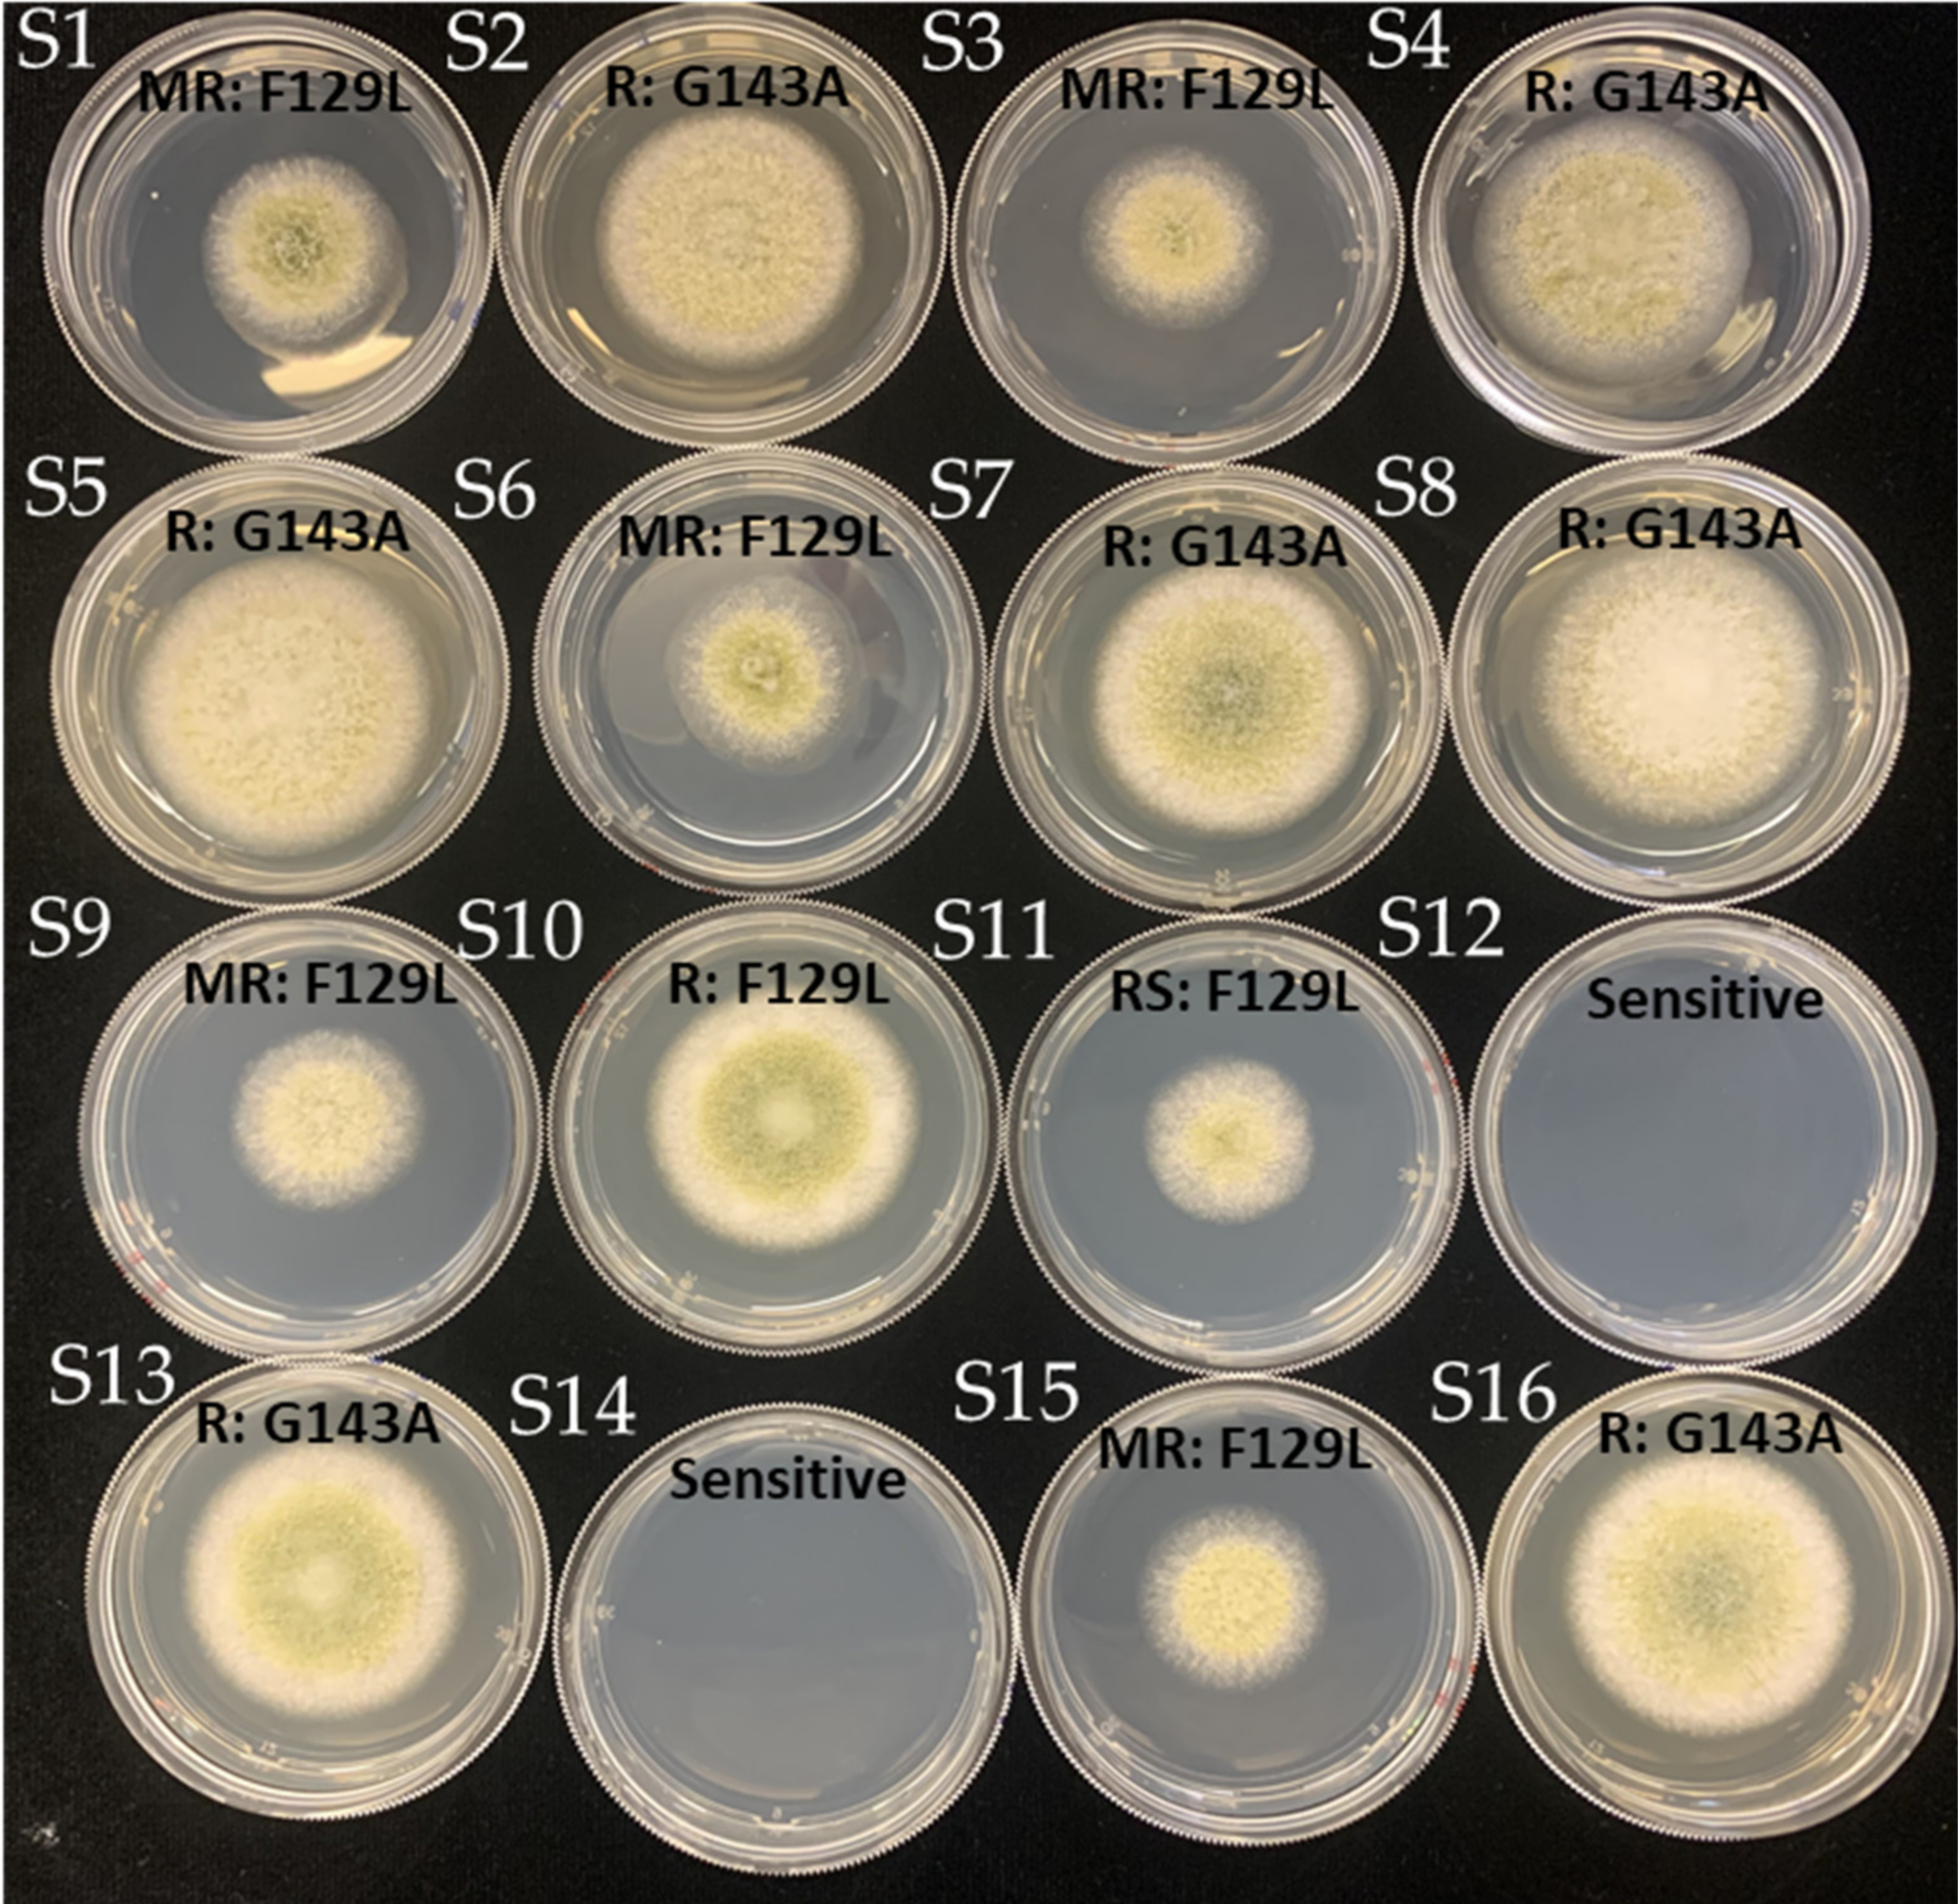

Sensitivity of Aspergillus flavus Isolates from Peanut Seeds in Georgia to Azoxystrobin, a Quinone outside Inhibitor (QoI) Fungicide
Abstract
1. Introduction
2. Materials and Methods
2.1. Collection of Fungal Isolates and Chemicals
2.2. DNA Isolation and Molecular Identification
2.3. In Vitro Assessment of Fungicide Sensitivity
2.4. Amplification and Sequencing of the Cytochrome B Gene
2.5. Resistance Phenotype Using Discriminatory Dose
3. Results
3.1. Fungal ID Confirmation
3.2. In Vitro Assay of A. flavus Isolates to Azoxystrobin
3.3. Detection of F129L and G143A Mutations
3.4. Mutations and EC50 Sensitivity to Azoxystrobin
3.5. Azoxystrobin Discriminatory Dose and Resistance Phenotype
4. Discussion
Supplementary Materials
Author Contributions
Funding
Institutional Review Board Statement
Informed Consent Statement
Data Availability Statement
Acknowledgments
Conflicts of Interest
Abbreviations
| AZOXY | azoxystrobin |
| PDA | potato dextrose agar |
| SHAM | salicylhydroxamic acid |
| QoI | quinone outside inhibitor |
| EC50 | effective concentration inhibiting 50% growth |
| CYTB | cytochrome b |
| ppm | parts per million |
References
- Dang, P.M.; Lamb, M.C.; Chen, C.Y. Association of differentially expressed R-gene candidates with leaf spot resistance in peanut (Arachis hypogaea L.). Mol. Biol. Rep. 2021, 48, 323–334. [Google Scholar] [CrossRef]
- Fletcher, S.M.; Shi, Z. An Overview of World Peanut Markets. In Peanuts; Stalker, H.T., Wilson, R.F., Eds.; AOCS Press: Champaign, IL, USA, 2016; Chapter 10; pp. 267–287. [Google Scholar]
- U.S. Department of Agriculture, National Agricultural Statistics Service. Crops and Plant Statistics; Department of Agriculture, National Agricultural Statistics Service: Washington, DC, USA, 2020. Available online: http://www.nass.usda.gov/ (accessed on 18 March 2021).
- Mallikarjuna, G.; Rao, T.S.R.B.; Kirti, P.B. Genetic engineering for peanut improvement: Current status and prospects. Plant Cell Tissue Organ Cult. 2020, 125, 399–416. [Google Scholar] [CrossRef]
- Amaike, S.; Keller, N.P. Aspergillus flavus. Annu. Rev. Phytopathol. 2011, 49, 107–133. [Google Scholar] [CrossRef]
- Diener, U.L.; Cole, R.J.; Sanders, T.H.; Payne, G.A.; Lee, L.S.; Klitch, M.A. Epidemiology of Aflatoxin Formation by Aspergillus flavus. Annu. Rev. Phytopathol. 1987, 25, 249–270. [Google Scholar] [CrossRef]
- Cantonwine, E.G.; Holbrook, C.C.; Culbreath, A.K.; Tubbs, R.S.; Boudreau, M.A. Genetic and Seed Treatment Effects in Organic Peanut. Peanut Sci. 2011, 38, 115–121. [Google Scholar] [CrossRef]
- Robens, J.F.; Richard, J.L. Aflatoxins in Animal and Human Health. In Reviews of Environmental Contamination and Toxicology; Ware, G.W., Ed.; Springer: New York, NY, USA, 1992; Volume 127. [Google Scholar]
- Bennett, J.W.; Klich, M.A. Mycotoxins. Clin. Microbiol. Rev. 2003, 16, 497–516. [Google Scholar] [CrossRef] [PubMed]
- Squire, R.A. Rating animal carcinogens: A proposed regulatory approach. Science 1981, 214, 877–880. [Google Scholar] [CrossRef] [PubMed]
- Klich, M.A. Aspergillus flavus: The major producer of aflatoxin. Mol. Plant Pathol. 2007, 8, 713–722. [Google Scholar] [CrossRef]
- Wicklow, D.T.; Wilson, D.M.; Nelsen, T.C. Survival of Aspergillus flavus sclerotia and conidia buried in soil in Illinois or Georgia. Phytopathology 1993, 83, 1141–1147. [Google Scholar] [CrossRef]
- Cotty, P.J. Cottonseed losses and mycotoxins. In Compendium of Cotton Diseases; Rothrock, C.S., Kirkpatrick, T.L., Eds.; American Phytopathological Society: St. Paul, MN, USA, 2001; pp. 9–13. [Google Scholar]
- Horn, B.W.; Pitt, J.I. Yellow mold and aflatoxin. In Compendium of Peanut Diseases; Kokalis, N., Burelle, D.M., Porter, R., Rodriguez-Kabana, D.H., Smith, S., Eds.; American Phytopathological Society: St. Paul, MN, USA, 1997; pp. 44–49. [Google Scholar]
- Cotty, P.J. Aflatoxin-producing potential of communities of Aspergillus section Flavi from cotton producing areas in the United States. Mycol. Res. 1997, 101, 698–704. [Google Scholar] [CrossRef]
- Brenneman, T.B.; Culbreath, A.K.; Ali, E. Increased Incidence of Aspergillus flavus in Peanut Seed. Proc. Am. Peanut Res. Educ. Soc. 2020, 52. In press. [Google Scholar]
- Ma, Z.; Felts, D.; Michailides, T.J. Resistance to azoxystrobin in Alternaria isolates from pistachio in California. Pestic. Biochem. Phys. 2003, 77, 66–74. [Google Scholar] [CrossRef]
- Rideout, S.L.; Brenneman, T.B.; Culbreath, A.K. Peanut disease management utilizing an infurrow treatment of Azoxystrobin. Plant Health Prog. 2002, 3. [Google Scholar] [CrossRef]
- Jiang, J.H.; Ding, L.S.; Michailides, T.J.; Li, H.Y.; Ma, Z.H. Molecular characterization of field azoxystrobin-resistant isolates of Botrytis cinerea. Pestic. Biochem. Phys. 2009, 93, 72–76. [Google Scholar] [CrossRef]
- Fraaije, B.A.; Cools, H.J.; Fountaine, J.D.; Lovell, J.; Motteram, J.; West, J.S.; Lucas, J.A. Role of ascospores in further QoI-resistant cytochrome b alleles (G143A) in field populations Mycosphaerella graminicola. Phytopathology 2005, 95, 933–941. [Google Scholar] [CrossRef] [PubMed]
- Ishii, H.; Fraaije, B.A.; Sugiyama, T.; Noguchi, K.; Nishimura, K.; Takeda, T.; Amano, T.; Hollomon, D.W. Occurrence and molecular characterization of strobilurin resistance in cucumber powdery mildew and downy mildew. Phytopathology 2011, 91, 1166–1171. [Google Scholar] [CrossRef] [PubMed]
- Baumler, S.; Felsenstein, F.G.; Schwarz, G. CAPS and DHPLC analysis of a single nucleotide polymorphism in the cytochrome b gene conferring resistance to strobilurins in field isolates of Blumeria graminis f. sp. hordei. J. Phytopathol. 2003, 151, 149–152. [Google Scholar] [CrossRef]
- Ali, M.E.; Hudson, O.; Waliullah, S.; Cook, J.; Brannen, M.P. Sensitivity of Colletotrichum isolates collected from strawberries in Georgia to pyraclostrobin, a quinone outside inhibitor (QoI) fungicide. Plant Health Prog. 2020, 21, 69–70. [Google Scholar] [CrossRef]
- Ali, M.E.; Pandit, L.K.; Mulvaney, K.A.; Amiri, A. Sensitivity of Phacidiopycnis spp. isolates from pome fruit to six pre- and postharvest fungicides. Plant Dis. 2018, 102, 533–539. [Google Scholar] [CrossRef]
- Ali, E.M.; Amiri, A. Selection pressure pathways and mechanisms of resistance to the demethylation inhibitor-difenoconazole in Penicillium expansum. Front. Microbiol. 2018, 9, 2472. [Google Scholar] [CrossRef]
- González-Salgado, A.; González-Jaén, T.; Vázquez, C.; Patiño, B. Highly sensitive PCR-based detection method specific for Aspergillus flavus in wheat flour. Food Addit. Contam. Part A 2008, 25, 758–764. [Google Scholar] [CrossRef]
- Ishii, H.; Yano, K.; Date, H.; Furuta, A.; Sagehashi, Y.; Yamaguchi, T.; Sugiyama, T.; Nishimura, K.; Hasama, W. Molecular characterization and diagnosis of QoI resistance in cucumber and eggplant fungal pathogens. Phytopathology 2007, 97, 1458–1466. [Google Scholar] [CrossRef]
- Vincelli, P.; Dixon, E. Resistance to QoI (strobilurin-like) fungicides in isolates of Pyricularia grisea from perennial ryegrass. Plant Dis. 2002, 86, 235–240. [Google Scholar] [CrossRef] [PubMed][Green Version]
- Jordan, B.S.; Arias, R.S.; Culbreath, A.K. Evaluation of QoI sensitivity in Aspergillus spp. section Nigri from peanut fields in Georgia. Proc. Am. Peanut Res. Educ. Soc. 2019, 51. In press. [Google Scholar]
- Veloukas, T.; Kalogeropoulou, P.; Markoglou, A.N.; Karaoglanidis, G.S. Fitness and competitive ability of Botrytis cinerea field isolates with dual resistance to SDHI and QoI fungicides, associated with several sdhB and the cytb G143A mutations. Phytopathology 2014, 104, 347–356. [Google Scholar] [CrossRef]
- Vega, B.; Dewdney, M.M. Distribution of QoI resistance in populations of tangerine-infecting Alternaria alternata in Florida. Plant Dis. 2014, 98, 67–76. [Google Scholar] [CrossRef]
- Leiminger, J.H.; Adolf, B.; Haudladen, H. Occurrence of the F129L mutation in Alternaria solani populations in Germany in response to QoI application, and its effect on sensitivity. Plant Pathol. 2014, 63, 640–650. [Google Scholar] [CrossRef]
- Van den Bosch, F.; Fraaije, B.; Oliver, R.; van den Berg, F.; Paveley, N. The use of mathematical models to guide fungicide resistance management decisions. In Fungicide Resistance in Plant Pathogens; Ishii, H., Hollomon, D.W., Eds.; Springer: Tokyo, Japan, 2007; pp. 49–62. [Google Scholar]
- Gisi, U.; Sierotzki, H.; Cook, A.; McCaffery, A. Mechanisms influencing the evolution of resistance to Qo inhibitor fungicides. Pest Manag. Sci. 2002, 58, 859–867. [Google Scholar] [CrossRef] [PubMed]
- Sierotzki, H.; Wullschleger, J.; Gisi, U. Point Mutation in Cytochrome b Gene Conferring Resistance to Strobilurin Fungicides in Erysiphe graminis f. sp. tritici field isolates. Pestic. Biochem. Phys. 2000, 68, 107–122. [Google Scholar] [CrossRef]
- Brent, K.J.; Holloman, D.W. Fungicide Resistance: The Assessment of Risk; Fungicide Resistance Action Committee: Brussels, Belgium, 2007. [Google Scholar]
- Markoglou, A.N.; Malandrakis, A.A.; Vitoratos, A.G.; Ziogas, B.N. Characterization of laboratory mutants of Botrytis cinerea resistant to QoI fungicides. Eur. J. Plant Pathol. 2006, 115, 149–162. [Google Scholar] [CrossRef]
- Dallabona, C.; Pioli, M.; Spadola, G.; Orsoni, N.; Bisceglie, F.; Lodi, T.; Pelosi, G.; Restivo, F.M.; Degola, F. Sabotage at the Powerhouse? Unraveling the Molecular Target of 2-Isopropylbenzaldehyde Thiosemicarbazone, a Specific Inhibitor of Aflatoxin Biosynthesis and Sclerotia Development in Aspergillus flavus, Using Yeast as a Model System. Molecules 2019, 24, 2971. [Google Scholar] [CrossRef] [PubMed]

| A. Flavus Isolates to Azoxystrobin (Based on the Mycelial Growth Inhibition) | |
|---|---|
| Mean EC50 | 9.07 μg/mL |
| Range EC50 | 0.12–297.22 μg/mL |
| VF * | 2476.83 |
| Isolate Type | EC50 (μg/mL) | ||
|---|---|---|---|
| Mean | Range | VF | |
| Non-mutated isolates | 0.98 | 0.9–1.77 | 1.97 |
| F129L isolates | 50.30 | 1.98–182.99 | 92.42 |
| G143A isolates | 113.83 | 3.16–297.22 | 94.06 |
| Sensitivity to Azoxystrobin with Four Key Relative Growth Inhibition (RGI) (%) Ranges | # of Isolates with Percentage (%) of Individual Group | ||
|---|---|---|---|
| With G143A Mutation | With F129L Mutation | Without Mutation | |
| Resistant (0–14%) | 24 (86%) | 6 (50%) | 0 (0%) |
| Moderately resistant (15–50%) | 4 (14%) | 4 (33%) | 0 (0%) |
| Reduced sensitivity (51–75%) | 0 (0%) | 2 (17%) | 2 (6%) |
| Sensitive (76–100%) | 0 (0%) | 0 (0%) | 34 (94%) |
Publisher’s Note: MDPI stays neutral with regard to jurisdictional claims in published maps and institutional affiliations. |
© 2021 by the authors. Licensee MDPI, Basel, Switzerland. This article is an open access article distributed under the terms and conditions of the Creative Commons Attribution (CC BY) license (https://creativecommons.org/licenses/by/4.0/).
Share and Cite
Ali, M.E.; Gunn, M.; Stackhouse, T.; Waliullah, S.; Guo, B.; Culbreath, A.; Brenneman, T. Sensitivity of Aspergillus flavus Isolates from Peanut Seeds in Georgia to Azoxystrobin, a Quinone outside Inhibitor (QoI) Fungicide. J. Fungi 2021, 7, 284. https://doi.org/10.3390/jof7040284
Ali ME, Gunn M, Stackhouse T, Waliullah S, Guo B, Culbreath A, Brenneman T. Sensitivity of Aspergillus flavus Isolates from Peanut Seeds in Georgia to Azoxystrobin, a Quinone outside Inhibitor (QoI) Fungicide. Journal of Fungi. 2021; 7(4):284. https://doi.org/10.3390/jof7040284
Chicago/Turabian StyleAli, Md Emran, Mackenzie Gunn, Tammy Stackhouse, Sumyya Waliullah, Baozhu Guo, Albert Culbreath, and Timothy Brenneman. 2021. "Sensitivity of Aspergillus flavus Isolates from Peanut Seeds in Georgia to Azoxystrobin, a Quinone outside Inhibitor (QoI) Fungicide" Journal of Fungi 7, no. 4: 284. https://doi.org/10.3390/jof7040284
APA StyleAli, M. E., Gunn, M., Stackhouse, T., Waliullah, S., Guo, B., Culbreath, A., & Brenneman, T. (2021). Sensitivity of Aspergillus flavus Isolates from Peanut Seeds in Georgia to Azoxystrobin, a Quinone outside Inhibitor (QoI) Fungicide. Journal of Fungi, 7(4), 284. https://doi.org/10.3390/jof7040284

